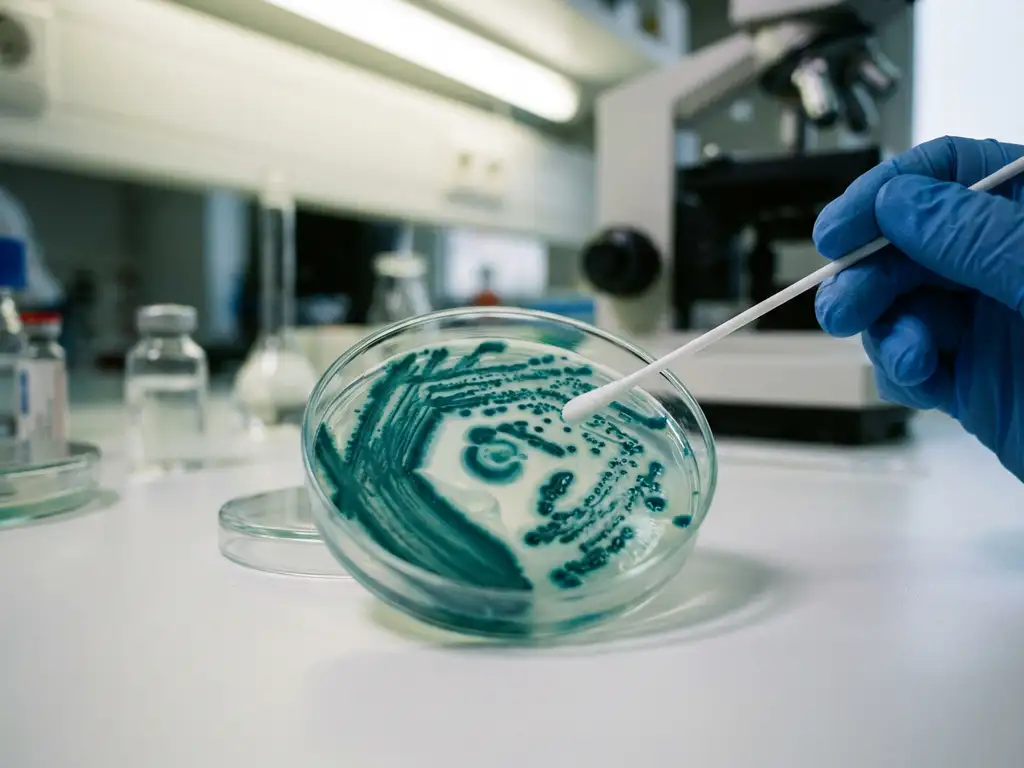
Scientist's gloved hand holding swab above petri dish with teal bacterial colonies on laboratory bench

The difference between in vivo and ex vivo gut microbiome testing lies in their testing environments and methodologies. In vivo testing occurs within living organisms, typically humans or animals, while ex vivo testing takes place outside the body under controlled laboratory conditions using preserved biological samples. Both approaches serve distinct purposes in gut microbiome research, with varying levels of complexity, cost, and predictive accuracy for product development.
What exactly are in vivo and ex vivo gut microbiome testing methods?
In vivo gut microbiome testing involves studying microbial communities within living organisms, including human clinical trials and animal studies. This approach examines how interventions affect the microbiome in its natural biological environment, capturing real-world interactions between the host and the microbial ecosystem.
Ex vivo testing, conversely, uses biological samples removed from their natural environment but maintained under controlled laboratory conditions. In gut microbiome research, this typically involves fresh faecal samples that preserve the original microbial community structure and function. The key principle behind ex vivo testing is maintaining the microbiome “as if it were a biopsy,” preserving both taxonomic composition and metabolic activity.
These methods serve different research objectives. In vivo approaches capture the full complexity of host–microbiome interactions over extended periods, while ex vivo methods focus on immediate microbial responses to specific interventions under standardised conditions.
How do in vivo and ex vivo testing approaches actually work?
In vivo testing requires administering test products to living subjects over weeks or months, then collecting samples at various time points to assess changes in microbial composition, metabolite production, and host biomarkers. This process involves extensive ethical approvals, participant recruitment, and long observation periods to capture meaningful biological changes.
Ex vivo testing operates through controlled fermentation systems using fresh microbiome samples. The process begins with sample collection, followed by immediate processing under anaerobic conditions that mimic the gut environment. Advanced ex vivo systems can generate insights within 24–48 hours, capturing immediate microbial responses that predict longer-term clinical outcomes.
The timeline differences are substantial. In vivo studies typically require 8–12 weeks to yield meaningful results, while ex vivo approaches can provide predictive data within days. This acceleration occurs because microbiome modulation happens immediately at the cellular level: gut bacteria respond to environmental changes within hours, altering their growth rates and metabolic activity.
What are the main advantages and limitations of each testing method?
In vivo testing offers the advantage of capturing complete biological complexity, including host immune responses, gut barrier function, and systemic metabolic changes. However, it faces significant limitations, including high costs (often £500,000–£5 million per study), lengthy timelines, ethical considerations, and substantial inter-individual variability that can obscure results.
Ex vivo testing provides several key benefits: dramatically reduced costs (60–80% less expensive than animal studies), rapid data generation, high reproducibility through standardised conditions, and the ability to test multiple conditions simultaneously. The main limitations include the inability to capture long-term host adaptations and the need for careful validation to ensure clinical relevance.
Ethical considerations increasingly favour ex vivo approaches. Modern regulatory frameworks, including the FDA Modernization Act 2.0, actively promote non-animal testing methods. The 3R principle (Replacement, Reduction, Refinement) supports moving away from animal models, particularly given that animal microbiomes differ substantially from human microbiomes in taxonomic composition, digestive physiology, and metabolic processes.
Which testing method provides more reliable results for product development?
Reliability depends on the research question and development stage. For clinical efficacy claims, in vivo human trials remain the gold standard. However, for mechanistic understanding and preclinical screening, validated ex vivo systems can provide highly predictive results when properly implemented.
The key to reliable ex vivo testing lies in validation studies demonstrating correlation between laboratory results and clinical outcomes. A truly reliable ex vivo system must maintain the original donor microbiome composition throughout testing, confirmed by running parallel no-substrate controls. Preserving individual donor characteristics forms the foundation of clinical predictivity.
Regulatory agencies increasingly recognise high-quality ex vivo data as valuable supporting evidence for product submissions to bodies such as EFSA and the FDA. These data are particularly valuable for demonstrating biological plausibility and mechanism of action under physiologically relevant conditions, significantly strengthening regulatory dossiers.
When should researchers choose in vivo versus ex vivo testing?
Choose ex vivo testing for early-stage product development, mechanistic studies, dose–response relationships, and when testing multiple formulations simultaneously. This approach excels when you need rapid screening capabilities, cost-effective evaluation of numerous candidates, or detailed analysis of responder versus non-responder profiles across diverse populations.
In vivo testing becomes essential for final efficacy validation, regulatory submissions requiring clinical data, safety assessments, and when studying long-term health outcomes. It is particularly important when investigating complex host–microbiome interactions that cannot be fully captured under laboratory conditions.
Budget and timeline constraints often drive the decision. Ex vivo studies can cost 10–40 times less than clinical trials while providing valuable predictive insights. A strategic approach involves using ex vivo testing to identify and rank promising candidates, then validating top performers through targeted in vivo studies. This reduces the risk of expensive clinical trial failures by ensuring that only the most promising interventions advance to human testing.
How Cryptobiotix advances ex vivo gut microbiome testing
Our SIFR® technology addresses traditional limitations of ex vivo testing through validated simulation methods that bridge the gap between preclinical data and clinical outcomes. Unlike conventional approaches that suffer from in vitro bias or oversimplified models, SIFR® maintains fresh, unmodified human gut microbiota samples as if they were biopsies, preserving both structure and function throughout the fermentation process.
Key advantages of our approach include:
- Validated clinical predictivity demonstrated through scientific publications showing correlation with human trial outcomes
- High-throughput automation processing over 1,000 bioreactors per week for comprehensive population studies
- A minimum of 6–8 donors per cohort, ensuring reliable statistical analysis and responder/non-responder insights
- Rapid data generation within 24–48 hours, capturing immediate microbial responses that drive long-term clinical benefits
- Multi-omics analysis providing mechanistic insights for regulatory submissions and IP generation
Our technology serves multiple applications across functional foods, pharmaceuticals, and biotechnology, helping companies de-risk product development and accelerate time to market. Whether you are screening early-stage candidates or generating comprehensive mechanistic data for regulatory dossiers, our SIFR® platform delivers the predictive insights needed to make informed development decisions.
Ready to transform your preclinical gut microbiome research? Contact our team to discuss how SIFR® technology can accelerate your product development while reducing costs and clinical trial risks.
Frequently Asked Questions
How do I determine if my product is a good candidate for ex vivo testing before investing in clinical trials?
Look for products with clear mechanistic hypotheses about microbiome modulation, such as prebiotics, probiotics, or bioactive compounds. Ex vivo testing is particularly valuable if you need to understand dose-response relationships, identify responder populations, or compare multiple formulations. A good candidate should have a plausible biological mechanism that can be measured through microbial growth, metabolite production, or community composition changes.
What sample size and donor diversity should I expect for reliable ex vivo gut microbiome studies?
For statistically meaningful results, aim for a minimum of 6-8 diverse donors per study cohort, though 10-12 donors provide more robust data for population-level insights. Donor diversity should reflect your target population, considering factors like age, diet, geography, and health status. This approach allows you to identify responder versus non-responder profiles and understand how individual microbiome differences affect product efficacy.
Can ex vivo results actually predict clinical trial outcomes, and what validation should I look for?
High-quality ex vivo systems can predict clinical outcomes when properly validated, but not all platforms are equal. Look for providers who can demonstrate published correlations between their ex vivo data and human clinical trial results. The system should maintain original donor microbiome composition throughout testing, use physiologically relevant conditions, and include appropriate controls to ensure data reliability.
What are the most common mistakes companies make when transitioning from ex vivo to in vivo studies?
The biggest mistake is assuming that ex vivo effective doses will directly translate to clinical doses without considering bioavailability, host metabolism, and delivery mechanisms. Companies also often underestimate the importance of selecting the right patient population based on ex vivo responder profiles. Additionally, failing to align ex vivo endpoints with clinically meaningful biomarkers can lead to disconnected data sets that don't support regulatory submissions.
How should I integrate ex vivo data into regulatory submissions for gut health claims?
Use ex vivo data to demonstrate biological plausibility and mechanism of action, supporting your clinical evidence rather than replacing it. Present the data as mechanistic validation that explains how your product works at the microbiome level, including specific bacterial targets, metabolite production, and dose-response relationships. This strengthens your regulatory dossier by providing scientific rationale for observed clinical effects and can help address regulatory questions about product consistency and quality.